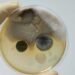
Understanding the Limitations of Home Mold Test Kits: What You Need to Know

Mold-related skin issues can be a serious problem for some people. While everyone is exposed to mold to some degree, some individuals are more susceptible to skin reactions caused by mold exposure. These reactions can range from mild to severe, and may include itching, redness, and hives.

Several factors can contribute to an individual’s susceptibility to mold-related skin issues. One of the most significant factors is a weakened immune system. People with weakened immune systems, such as those with HIV/AIDS or cancer, are more susceptible to mold-related skin issues because their bodies are less able to fight off infections. Additionally, people with allergies or asthma may be more susceptible to mold-related skin issues because their immune systems are already overactive.
Another factor that can contribute to an individual’s susceptibility to mold-related skin issues is genetics. According to Dr. Sara Gottfried, approximately 24% of the population is genetically vulnerable to mold toxicity due to a certain immune response gene (HLA-DR). This gene can make it more difficult for the body to eliminate mycotoxins, which are toxins produced by certain types of mold.
Key Takeaways
- Mold-related skin issues can range from mild to severe and may include itching, redness, and hives.
- People with weakened immune systems and those with allergies or asthma may be more susceptible to mold-related skin issues.
- Genetics can also play a role in an individual’s susceptibility to mold-related skin issues.
Understanding Mold and Its Habitats
Mold is a type of fungi that can grow both indoors and outdoors. It thrives in moist environments and can grow on a variety of surfaces, including wood, drywall, and insulation. Mold reproduces by releasing spores into the air, which can be harmful when inhaled or come into contact with the skin.
Mold Growth Factors
Mold requires three things to grow: moisture, food, and the right temperature. The ideal temperature for mold growth is between 60 and 80 degrees Fahrenheit. Mold can grow on any organic material, including paper, fabric, and wood.
Common Mold Infested Areas
Mold can grow in any area that is damp or humid. Common areas for mold growth include bathrooms, kitchens, and basements. Mold can also grow in areas that have experienced flooding or water damage.
The EPA recommends keeping indoor humidity levels between 30 and 60 percent to prevent mold growth. Homeowners should repair any plumbing leaks and use exhaust fans in bathrooms and kitchens to reduce moisture. Clothes dryers should be vented to the outside to prevent moisture buildup. House plants should be regularly checked for mold growth, and any contaminated soil should be removed.
Ceiling tiles, insulation, and drywall that have been affected by mold should be removed and replaced. Moldy clothing and other porous materials should be discarded. Non-porous surfaces such as glass, plastic, and metal can be cleaned with a solution of bleach and water to remove mold.
By understanding the factors that contribute to mold growth and taking steps to prevent it, homeowners can reduce their risk of mold-related skin issues and other health problems associated with exposure to mold spores.
Health Effects of Mold Exposure
Mold exposure can cause a variety of health effects, ranging from mild to severe. The severity of the health effects depends on the individual’s sensitivity to mold, the type of mold, and the duration of exposure.
Respiratory and Skin Reactions
Respiratory reactions are the most common health effects associated with mold exposure. These reactions include coughing, wheezing, congestion, runny nose, and sneezing. In some cases, mold exposure can also cause respiratory conditions such as asthma and bronchitis. Individuals with compromised immune systems, such as HIV infection, are at a higher risk of developing infections in their lungs from mold exposure.
Skin reactions are less common but can occur in some individuals. These reactions include skin rash, itching, and irritation. Prolonged exposure to mold can cause chronic skin conditions, such as eczema.
Vulnerable Populations
Certain populations are more vulnerable to the health effects of mold exposure. Infants, elderly people, and individuals with chronic illnesses are at a higher risk of developing health problems from mold exposure. Additionally, individuals with allergies to mold or with asthma may have more intense allergic reactions to mold exposure.
To prevent mold-related health issues, it is important to control moisture in the home. This includes fixing leaks, reducing humidity, and ensuring proper ventilation in areas such as basements and bathrooms. Individuals with allergies to mold or with asthma should wear N95 masks when cleaning moldy areas to prevent allergic reactions.
In addition to respiratory and skin reactions, mold exposure can also cause eye irritation, nosebleeds, fatigue, and fever. Some types of mold produce mycotoxins, which can cause more severe health effects. It is important to take mold odors seriously and to address any mold issues promptly to prevent health problems.
Identifying Mold in Your Environment

Mold is a type of fungus that can grow on various surfaces in your home, including walls, ceilings, carpets, and furniture. It can be difficult to detect mold growth since it often grows in hidden areas, such as inside walls or under carpets. However, there are a few ways to identify mold in your environment.
Visual Inspection
Visual inspection is the most common method for identifying mold growth in your home. Mold growth can appear in different colors, including black, green, white, or brown, and can have a fuzzy or slimy appearance. Mold can also have a musty odor, which can help in identifying its presence.
When inspecting your home for mold growth, it is important to check areas that are prone to moisture, such as bathrooms, kitchens, and basements. Look for signs of water damage, such as discoloration or warping on walls or ceilings. If you notice any of these signs, it is important to address the issue promptly to prevent mold growth.
Mold Testing Procedures
If you suspect that you have a mold problem in your home, you may want to consider mold testing procedures. Mold testing can help to identify the type of mold present in your home and the spore levels. This information can be helpful in determining the severity of the mold problem and the appropriate course of action.
There are different types of mold testing procedures, including air sampling, surface sampling, and bulk sampling. Air sampling involves collecting air samples to measure the concentration of mold spores in the air. Surface sampling involves collecting samples from surfaces in your home, such as walls or floors. Bulk sampling involves collecting samples of materials, such as drywall or insulation, that may contain mold.
It is recommended to hire a qualified mold testing contractor to perform mold testing procedures in your home. A qualified contractor can provide accurate results and recommendations on how to address any mold problems that are identified.
In summary, identifying mold growth in your environment is important for maintaining a healthy living space. Visual inspection and mold testing procedures are effective methods for identifying mold growth and determining the appropriate course of action. It is important to address any mold problems promptly to prevent further growth and potential health issues.
Prevention and Control of Mold

Mold can cause a variety of health issues, including skin problems. Therefore, it is essential to prevent and control mold growth in homes and other buildings. Here are some measures that can help prevent and control mold growth:
Moisture and Humidity Management
Mold thrives in moist and warm environments. Therefore, it is essential to control moisture and humidity levels in the home. The following measures can help:
- Fix plumbing leaks immediately.
- Use a dehumidifier to maintain humidity levels below 60%.
- Ventilate bathrooms and kitchens by using exhaust fans or opening windows.
- Avoid overwatering houseplants.
- Dry clothes using a clothes dryer rather than air drying them indoors.
Building and Material Maintenance
Mold can grow on any surface that provides it with nutrients and moisture. Therefore, it is essential to maintain buildings and materials to prevent mold growth. The following measures can help:
- Repair any leaks in the roof, walls, or windows.
- Clean and dry any wet materials within 48 hours.
- Remove any moldy materials and clean the affected area with a solution of bleach and water.
- Use mold-resistant building materials, such as drywall and paint.
- Increase ventilation in areas prone to condensation, such as the attic or crawl space.
By implementing these measures, individuals can prevent and control mold growth in their homes and other buildings.
Cleaning and Removal of Mold

Mold can be a pesky problem that requires immediate attention. If left untreated, mold can cause serious health problems, especially for people with allergies or weakened immune systems. The cleaning and removal of mold can be done through DIY methods or by hiring professional mold removal services.
DIY Mold Remediation
If the mold problem is small, it can be easily remediated by the homeowner. First, it is important to identify the source of the mold growth and eliminate any standing water or moisture. Once the source is eliminated, the mold can be removed by scrubbing the affected area with a mixture of detergent and water. For tougher mold stains, a bleach solution can be used. It is important to wear a respirator to avoid inhaling mold spores during the cleaning process. After cleaning, the area should be thoroughly dried and disinfected with a disinfectant.
Professional Mold Removal Services
For larger mold problems, it is recommended to hire a professional mold removal service. These services have specialized equipment and expertise to remove mold safely and effectively. Professional mold removal services will identify the source of the mold growth, contain the affected area, remove the mold, and disinfect the area to prevent future mold growth. It is important to hire a reputable and certified mold removal service to ensure the job is done correctly.
In conclusion, cleaning and removal of mold can be done through DIY methods or by hiring professional mold removal services. It is important to identify the source of the mold growth and eliminate any standing water or moisture. For DIY methods, a mixture of detergent and water or a bleach solution can be used to remove the mold. It is important to wear a respirator to avoid inhaling mold spores during the cleaning process. For larger mold problems, it is recommended to hire a professional mold removal service to ensure the job is done correctly.
Health Precautions During Mold Removal
When removing mold from a home or building, it is important to take necessary health precautions to avoid any health risks. This is especially important for individuals who are more susceptible to mold-related skin issues due to their weakened immune system, allergies, or other health problems.
Protective Gear and Safety Measures
To protect against mold spores during mold removal, it is recommended to wear protective gear such as gloves, goggles, and a respirator. The U.S. Environmental Protection Agency (EPA) recommends using an N95 respirator or a half-face respirator with replaceable filters to protect against inhalation of mold spores.
When cleaning mold, it is important to use appropriate cleaning solutions, such as a bleach solution or detergent, to disinfect and remove mold. However, it is important to follow proper safety measures when using bleach, as it can be harmful if not used correctly.
Special Considerations for High-Risk Individuals
Individuals with weakened immune systems, allergies, or other health problems should take special precautions during mold removal. Chemotherapy patients, organ transplant recipients, and individuals with chronic lung disease are at a higher risk of developing serious health problems from exposure to mold.
These individuals should avoid being present during mold removal and should leave the area until the cleanup is complete. It is also recommended to consult with a healthcare provider before returning to the environment where mold was present.
In conclusion, taking proper health precautions during mold removal is essential to avoid any health risks, especially for high-risk individuals. By wearing protective gear, using appropriate cleaning solutions, and following proper safety measures, individuals can safely remove mold from their homes or buildings without any adverse health effects.
Legal and Insurance Considerations
Mold Disclosure Requirements
When it comes to mold, disclosure requirements vary significantly from state to state. Some states require that sellers disclose any known mold problems to potential buyers, while others do not. In general, however, it is always a good idea to disclose any known mold problems to potential buyers, as failure to do so could result in legal action being taken against the seller.
The U.S. Environmental Protection Agency (EPA) provides guidelines for mold remediation, which contractors should follow to ensure that they are addressing the mold problem effectively. Property owners should also ensure that they are working with a reputable contractor who is licensed and insured, as this will help to protect them in the event that something goes wrong during the remediation process.
Insurance Coverage for Mold Damage
Homeowners insurance policies may cover mold damage in certain circumstances. For example, if the mold is caused by a covered peril, such as a burst pipe or leaky appliance, it may be covered by the policy. However, mold damage resulting from humidity or other non-covered perils may not be covered.
It is important for homeowners to review their insurance policies carefully to determine whether mold damage is covered and to what extent. Some policies may offer limited coverage for mold damage, while others may require homeowners to purchase additional coverage through a rider.
In general, homeowners should take steps to prevent mold problems from occurring in the first place, such as addressing any water leaks or moisture problems promptly. This can help to reduce the risk of mold-related skin issues and other health problems, as well as minimize the need for costly mold remediation services.
Frequently Asked Questions
What are the common symptoms of mold-related skin reactions?
Skin reactions to mold may vary from person to person. Some of the common symptoms include itching, redness, and swelling of the skin. In some cases, skin reactions may also lead to hives, blisters, and even open sores.
How can long-term exposure to mold affect the skin?
Long-term exposure to mold can cause chronic skin irritation and inflammation. This can lead to skin damage, such as the development of wrinkles, fine lines, and age spots. In some cases, long-term exposure to mold can also lead to the development of skin cancer.
What are the typical signs that indicate a skin allergy to indoor mold?
The typical signs of a skin allergy to indoor mold include itching, redness, and swelling of the skin. In some cases, skin reactions may also lead to hives, blisters, and even open sores. Individuals with a skin allergy to indoor mold may also experience respiratory symptoms, such as sneezing, coughing, and wheezing.
Why do some individuals experience hives as a reaction to mold during the night?
Some individuals experience hives as a reaction to mold during the night due to increased exposure to mold spores while sleeping. This can lead to an allergic reaction, causing the body to release histamines, which can cause hives and other skin reactions.
What differentiates those with higher sensitivity to mold-related skin issues?
Individuals with higher sensitivity to mold-related skin issues often have a weakened immune system or pre-existing skin conditions. They may also have a genetic predisposition to mold allergies or may have been exposed to high levels of mold in the past.
How does mold exposure cause skin rashes and what are the treatment options?
Mold exposure can cause skin rashes by triggering an allergic reaction in the body. Treatment options for mold-related skin issues include topical creams and ointments, antihistamines, and in severe cases, corticosteroids. It is important to identify and eliminate the source of mold to prevent further exposure and skin reactions.